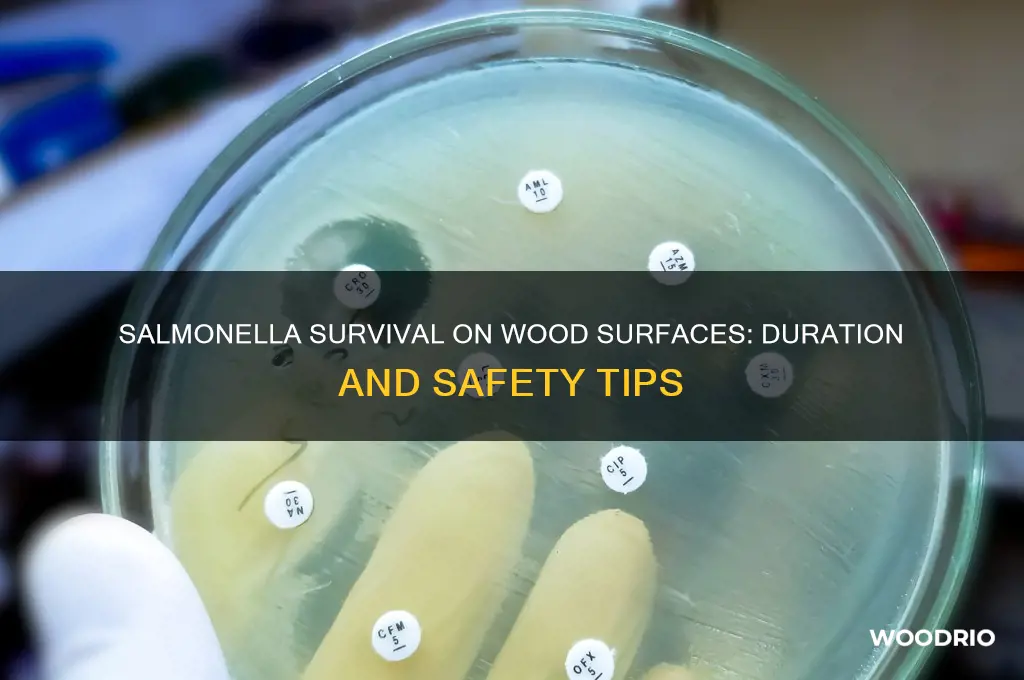
how long does salmonella live on wood

Salmonella, a common foodborne pathogen, can survive on various surfaces, including wood, raising concerns about its persistence and potential health risks. Understanding how long Salmonella remains viable on wood is crucial for food safety, especially in environments like kitchens and cutting boards where cross-contamination is a risk. Factors such as temperature, humidity, and the type of wood can influence the bacteria's survival time, which typically ranges from several hours to several days. Proper sanitation and maintenance of wooden surfaces are essential to minimize the risk of Salmonella transmission and ensure a safe food preparation environment.
| Characteristics | Values |
|---|---|
| Survival Time on Wood (Dry Conditions) | Up to 4 weeks (28 days) |
| Survival Time on Wood (Moist Conditions) | Up to 1-2 weeks (7-14 days) |
| Factors Affecting Survival | Moisture, temperature, wood type, and bacterial load |
| Optimal Survival Temperature | 35-37°C (95-98.6°F) |
| Minimum Survival Temperature | Can survive at refrigeration temperatures (4°C/39°F) for shorter periods |
| Maximum Survival Temperature | Survives up to 55°C (131°F) but dies rapidly above this |
| Wood Porosity Influence | More porous wood may harbor bacteria longer |
| Disinfection Effectiveness | Proper cleaning and sanitizing (e.g., bleach solution) reduces survival |
| Cross-Contamination Risk | High if wood surfaces are not cleaned after contact with contaminated food |
| Common Wood Surfaces Affected | Cutting boards, countertops, utensils, and furniture |
Explore related products
What You'll Learn

Survival Duration on Wood Surfaces
Salmonella's survival on wood surfaces is influenced by factors such as moisture, temperature, and wood type. Research indicates that salmonella can persist on wood for up to 4 weeks under favorable conditions, particularly when the wood remains damp or in cooler environments. For instance, a study published in the *Journal of Food Protection* found that salmonella survived significantly longer on untreated pine compared to stainless steel, highlighting the porous nature of wood as a contributing factor.
To minimize the risk of salmonella contamination on wood surfaces, follow these practical steps: clean the wood thoroughly with hot, soapy water, and sanitize using a solution of 1 tablespoon of unscented bleach per gallon of water. Allow the surface to air dry completely, as moisture prolongs bacterial survival. For cutting boards or kitchen utensils, consider using hardwoods like maple or teak, which are less porous and easier to clean than softwoods. Regularly inspect wood surfaces for cracks or splinters, as these can harbor bacteria and make cleaning ineffective.
Comparing wood to other materials, such as plastic or metal, reveals distinct differences in salmonella survival. While salmonella may survive for only a few hours to a few days on non-porous surfaces like stainless steel, wood’s natural grooves and fibers provide a more hospitable environment. However, wood also has antimicrobial properties in some cases; for example, cedar and cypress contain natural oils that can inhibit bacterial growth. This duality underscores the importance of proper maintenance and material selection in food preparation areas.
For households with young children, elderly individuals, or immunocompromised family members, extra precautions are essential. Avoid using wooden cutting boards for raw meat or poultry, opting instead for disposable or easily disinfected materials. If wood must be used, designate separate boards for raw and cooked foods to prevent cross-contamination. Additionally, store wooden utensils and surfaces in a dry, well-ventilated area to discourage bacterial growth. By understanding salmonella’s survival dynamics on wood, you can implement targeted strategies to safeguard your home environment.
Weathering Cherry Wood: Optimal Outdoor Time for Rich Darkening Results
You may want to see also
Explore related products

Temperature Impact on Wood Contamination
Salmonella's survival on wood surfaces is significantly influenced by temperature, a critical factor often overlooked in food safety discussions. At room temperature (around 20-25°C or 68-77°F), Salmonella can persist on wood for up to 4 weeks, according to studies. This extended survival time is concerning, especially in environments like kitchens where wood cutting boards or utensils are frequently used. The porous nature of wood allows the bacteria to embed itself, making it harder to eradicate compared to non-porous surfaces like plastic or metal. Understanding this temperature-dependent survival is essential for implementing effective sanitation practices.
To mitigate Salmonella contamination on wood, temperature manipulation can be a strategic tool. Exposing wood surfaces to high temperatures, such as through dishwashers with drying cycles reaching 82°C (180°F) or higher, can significantly reduce bacterial survival. For instance, research shows that Salmonella is inactivated within 10 minutes at temperatures above 70°C (158°F). However, not all wood items can withstand such heat without warping or cracking. In these cases, alternative methods like using food-safe mineral oil to seal the wood and reduce bacterial penetration, followed by thorough air drying, can be employed. The key is to balance temperature-based disinfection with the material’s integrity.
Conversely, low temperatures also play a role in Salmonella’s survival on wood, though in a different manner. Refrigeration (4°C or 39°F) does not kill Salmonella but slows its growth, effectively extending its survival time on wood surfaces. This is particularly relevant in food storage areas where wood crates or shelves might be used. For example, Salmonella can remain viable on refrigerated wood surfaces for up to 3 months, compared to weeks at room temperature. To address this, regular cleaning with a mild bleach solution (1 tablespoon of bleach per gallon of water) and ensuring wood surfaces are completely dry before use can minimize risk.
Practical tips for managing temperature impact on wood contamination include monitoring ambient conditions in food preparation areas. In warmer climates or during summer months, wood surfaces should be cleaned more frequently, as higher temperatures can accelerate bacterial growth. Additionally, for households or businesses using wood extensively, investing in temperature-controlled storage solutions or UV-C light sanitizers can provide an extra layer of protection. UV-C light, for instance, has been shown to reduce Salmonella on surfaces by 99.9% within 10 minutes of exposure, offering a non-thermal alternative for disinfection.
In conclusion, temperature is a double-edged sword in the battle against Salmonella on wood surfaces. While high temperatures can effectively kill the bacteria, low temperatures prolong its survival, and moderate temperatures allow it to thrive. By understanding these dynamics, individuals and industries can adopt targeted strategies—whether through heat treatment, refrigeration management, or alternative disinfection methods—to ensure wood surfaces remain safe for food contact. This knowledge not only enhances food safety but also extends the lifespan of wood items by preventing unnecessary damage from improper cleaning practices.
Wood Pellets Lifespan: How Long Do They Last and Stay Effective?
You may want to see also
Explore related products

Moisture Effects on Salmonella Persistence
Salmonella's survival on wood surfaces is significantly influenced by moisture levels, a critical factor often overlooked in food safety discussions. High humidity or direct moisture exposure can extend the pathogen's lifespan, posing risks in kitchens and food processing environments. Understanding this relationship is essential for implementing effective sanitation practices.
Analytical Insight:
Moisture acts as a protective medium for Salmonella, enabling it to remain viable longer on wood surfaces. Studies show that at relative humidity levels above 50%, Salmonella can persist for up to 4 weeks on wood, compared to just 1–4 days in drier conditions (below 30% humidity). This is because moisture prevents desiccation, a primary mechanism that kills bacteria on dry surfaces. Additionally, wood’s porous nature traps moisture, creating microenvironments where Salmonella thrives. For instance, cutting boards used for raw poultry and left damp after cleaning can harbor the pathogen, increasing cross-contamination risks.
Practical Instructions:
To minimize Salmonella persistence on wood surfaces, follow these steps:
- Dry Thoroughly: After washing wooden utensils or surfaces, air-dry them completely or use a clean towel to remove all moisture.
- Condition Wood: Apply food-safe mineral oil monthly to cutting boards to reduce moisture absorption and create a less hospitable environment for bacteria.
- Monitor Humidity: Keep kitchen humidity below 50% using dehumidifiers, especially in food preparation areas.
- Replace Regularly: Discard heavily scratched or cracked wooden items, as these retain moisture and bacteria more effectively.
Comparative Perspective:
Unlike non-porous materials like stainless steel or plastic, wood’s organic composition interacts uniquely with moisture. While stainless steel surfaces may dry quickly, wood retains moisture longer, even after surface drying. This distinction highlights why wooden tools require more stringent drying protocols. For example, a damp wooden spoon left in a drawer can become a Salmonella reservoir, whereas a stainless steel spoon would pose less risk under the same conditions.
Descriptive Scenario:
Imagine a busy restaurant kitchen where wooden cutting boards are used for chopping vegetables after handling raw chicken. If these boards are rinsed but not dried properly, moisture seeps into the wood’s pores, providing a breeding ground for Salmonella. Over time, even with regular cleaning, the pathogen persists, leading to potential foodborne outbreaks. This scenario underscores the importance of moisture control in high-risk environments.
Persuasive Takeaway:
Ignoring moisture’s role in Salmonella persistence on wood is a recipe for contamination. By prioritizing thorough drying, regular maintenance, and humidity control, you can significantly reduce the risk of bacterial survival. Small changes in handling wooden surfaces can yield substantial improvements in food safety, protecting both your household and commercial operations.
Burnt Wood Durability: Does Charred Timber Outlast Untreated Wood?
You may want to see also

Wood Type and Bacterial Lifespan
The survival of Salmonella on wood surfaces is not a one-size-fits-all scenario. Different wood types, with their unique structures and properties, can significantly influence how long these bacteria persist. For instance, porous woods like pine or oak, with their open cell structures, may provide more hiding spots for Salmonella, potentially extending its survival time compared to denser, less absorbent woods like maple or cherry.
This variation highlights the importance of considering wood type when assessing bacterial contamination risks, especially in food preparation areas.
Imagine a cutting board, a kitchen staple often made from various woods. A study by the USDA found that Salmonella can survive on wooden cutting boards for up to 4 hours, but this timeframe can fluctuate based on the wood species. Harder, denser woods with tighter grain patterns tend to be less hospitable to bacteria due to reduced moisture absorption and fewer crevices for bacteria to cling to. This means a maple cutting board might be a slightly safer choice than a pine one, though proper cleaning and sanitation remain paramount regardless of wood type.
Practical Tip: To minimize bacterial growth, always wash wooden cutting boards with hot, soapy water after each use, and consider using separate boards for raw meat and other food items.
While wood type plays a role, it's crucial to remember that other factors also influence Salmonella's survival. Moisture content is key – damp wood provides a more favorable environment for bacterial growth than dry wood. Temperature also matters; Salmonella thrives in warmer conditions, so keeping wooden surfaces cool can help inhibit its survival. Caution: Never rely solely on wood type as a guarantee against bacterial contamination. Proper hygiene practices, including regular cleaning and disinfection, are essential for food safety.
Comparative Analysis: Think of wood type as one piece of the puzzle. While certain woods may offer slight advantages, they are not a substitute for diligent cleaning and sanitation practices.
Understanding the interplay between wood type and bacterial lifespan empowers us to make informed choices in food handling and surface selection. By considering the unique characteristics of different woods and implementing proper hygiene protocols, we can significantly reduce the risk of Salmonella contamination and promote a safer food environment.
Perfect Grilling: Soaking Wooden Skewers for Safe, Tasty Results
You may want to see also

Cleaning Methods to Eliminate Salmonella
Salmonella can survive on wood surfaces for up to 4 weeks under dry conditions, making it a persistent threat in kitchens and food preparation areas. This longevity underscores the importance of effective cleaning methods to eliminate the bacteria and prevent contamination. While wood’s porous nature complicates disinfection, targeted strategies can ensure thorough sanitation.
Step-by-Step Cleaning Protocol: Begin by removing visible debris from the wood surface using a damp cloth or brush. Follow this with a solution of hot water and dish soap, scrubbing vigorously to penetrate the wood’s pores. Rinse thoroughly to avoid soap residue, which can hinder further disinfection. Next, apply a food-safe sanitizer, such as a solution of 1 tablespoon of unscented bleach per gallon of water, allowing it to sit for at least 1 minute before rinsing. For non-bleach alternatives, use a vinegar solution (1 part vinegar to 4 parts water) or a commercial disinfectant labeled for food contact surfaces. Always test cleaning agents on a small area to prevent wood damage.
Cautions and Considerations: Avoid using excessive water, as prolonged moisture can warp wood and create an environment conducive to bacterial regrowth. Never mix bleach with ammonia or vinegar, as this produces toxic fumes. For cutting boards and utensils, consider sanding the surface periodically to remove top layers where bacteria may embed. Note that oil-based finishes or sealants can interfere with disinfection, so prioritize cleaning before applying such treatments.
Comparative Effectiveness of Methods: Bleach solutions are highly effective against Salmonella but may discolor or weaken wood over time. Vinegar, while gentler, requires longer contact time and may not be as potent. Commercial disinfectants often provide balanced efficacy and safety but can be costly. Steam cleaning, though less common, is an eco-friendly option that penetrates pores without chemicals, but it requires specialized equipment and careful handling to avoid burns.
Practical Tips for Prevention: Designate separate cutting boards for raw meats and produce to minimize cross-contamination. Store wood items in dry, well-ventilated areas to discourage bacterial survival. Regularly inspect wood surfaces for cracks or splinters, as these can harbor bacteria. For high-risk environments like commercial kitchens, establish a cleaning schedule with documented steps and frequency, ensuring compliance with food safety regulations. By combining thorough cleaning with preventive measures, the risk of Salmonella persistence on wood can be significantly reduced.
Durability of Rubber Wood: Lifespan, Care, and Longevity Explained
You may want to see also
Frequently asked questions
Salmonella can survive on wood surfaces for up to 4 weeks, depending on environmental conditions such as temperature, humidity, and the presence of organic matter.
Yes, the type of wood and its porosity can influence Salmonella survival. Rough or untreated wood may harbor bacteria longer than smooth or sealed surfaces.
Yes, proper cleaning and sanitizing of wood surfaces can significantly reduce or eliminate Salmonella, especially when using disinfectants or hot, soapy water.
Yes, Salmonella survives longer in cooler temperatures. Warmer conditions (above 90°F or 32°C) can shorten its survival time on wood surfaces.





















